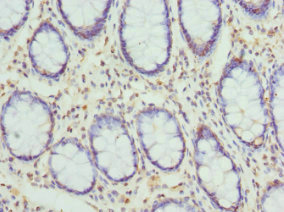

CYTH2 Antibody
-
中文名稱:CYTH2兔多克隆抗體
-
貨號:CSB-PA857445ESR2HU
-
規(guī)格:¥440
-
圖片:
-
Western blot
All lanes: CYTH2 antibody at 5.1µg/ml + MCF-7 whole cell lysate
Secondary
Goat polyclonal to rabbit IgG at 1/10000 dilution
Predicted band size: 47 kDa
Observed band size: 47 kDa -
Immunohistochemistry of paraffin-embedded human ovarian cancer using CSB-PA857445ESR2HU at dilution of 1:100
-
Immunohistochemistry of paraffin-embedded human colon cancer using CSB-PA857445ESR2HU at dilution of 1:100
-
-
其他:
產(chǎn)品詳情
-
產(chǎn)品名稱:Rabbit anti-Homo sapiens (Human) CYTH2 Polyclonal antibody
-
Uniprot No.:
-
基因名:
-
別名:ARF exchange factor antibody; ARF nucleotide binding site opener antibody; ARF nucleotide-binding site opener antibody; Arno antibody; ARNO protein antibody; CLM2 antibody; CTS18 antibody; CTS18.1 antibody; CYH2_HUMAN antibody; Cyth2 antibody; Cytohesin 2 antibody; Cytohesin-2 antibody; MGC137537 antibody; MGC80440 antibody; PH antibody; PH; SEC7 and coiled-coil domain-containing protein 2 antibody; Pleckstrin homology Sec7 and coiled coil domains 2 antibody; Pleckstrin homology Sec7 and coiled coil domains protein 2 antibody; Protein ARNO antibody; PSCD2 antibody; PSCD2L antibody; PSCD2L; formerly antibody; SEC7 and coiled-coil domain-containing protein 2 antibody; Sec7 antibody; SEC7 homolog B antibody; Sec7B antibody; SEC7L antibody; Sec7p L antibody; Sec7p-like antibody; Sec7pL antibody
-
宿主:Rabbit
-
反應(yīng)種屬:Human
-
免疫原:Recombinant Human Cytohesin-2 protein (150-350AA)
-
免疫原種屬:Homo sapiens (Human)
-
標(biāo)記方式:Non-conjugated
-
克隆類型:Polyclonal
-
抗體亞型:IgG
-
純化方式:Antigen Affinity Purified
-
濃度:It differs from different batches. Please contact us to confirm it.
-
保存緩沖液:PBS with 0.02% sodium azide, 50% glycerol, pH7.3.
-
產(chǎn)品提供形式:Liquid
-
應(yīng)用范圍:ELISA, WB, IHC
-
推薦稀釋比:
Application Recommended Dilution WB 1:1000-1:5000 IHC 1:20-1:200 -
Protocols:
-
儲存條件:Upon receipt, store at -20°C or -80°C. Avoid repeated freeze.
-
貨期:Basically, we can dispatch the products out in 1-3 working days after receiving your orders. Delivery time maybe differs from different purchasing way or location, please kindly consult your local distributors for specific delivery time.
-
用途:For Research Use Only. Not for use in diagnostic or therapeutic procedures.
相關(guān)產(chǎn)品
靶點詳情
-
功能:Acts as a guanine-nucleotide exchange factor (GEF). Promotes guanine-nucleotide exchange on ARF1, ARF3 and ARF6. Activates ARF factors through replacement of GDP with GTP. The cell membrane form, in association with ARL4 proteins, recruits ARF6 to the plasma membrane. Involved in neurite growth.
-
基因功能參考文獻:
- ARNO-ARF1 regulates formation of podosomes by inhibition of RhoA/myosin-II and promotion of actin core assembly. PMID: 28007915
- Authors' experiments argue against ARNO being a robust modifier of EGFR catalytic activity. PMID: 27203102
- Data establish a role for cytohesin-2/ARNO as a regulator of R-Ras and integrin recycling and suggest that ARF-regulated trafficking of R-Ras is required for R-Ras-dependent effects on spreading and adhesion formation. PMID: 26378252
- The authors show that Shigella flexneri IpgD phosphatase activity is required for recruitment of the ARF6 guanine nucleotide exchange factor (GEF) ARF nucleotide binding site opener (ARNO) to bacterial entry sites. PMID: 25736891
- inhibiting cytohesins or ARNO as cytoplasmic activators of EGFR and IGF-I in colorectal cancer resulted in anti-proliferation, reduced invasion, decreased migration, and suppressed growth in vivo and in vitro. PMID: 24618737
- Cytohesin-2 constitutively suppresses platelet dense granule secretion and aggregation by keeping ARF6 in a GTP-bound state PMID: 24581425
- Expression of CYTH2 mutant deficient of the EFh2 domain in cells also inhibits Arf6 activation and neurite extension. PMID: 22659138
- Phosphorylation of Ser392 of ARNO stabilized the C-terminal alpha-helix via formation of salt bridges between phospho-Ser392 and Arg390, Lys395, and Lys396. PMID: 24083777
- There is an association between cytohesin-2 expression and overall survival and disease-free survival in patients with hepatocellular carcinoma. PMID: 23545718
- Arf6/ ARNO signaling mediates phospholipase-D, ERK1/2 and cofilin activation in pancreatic beta-cells. PMID: 23095975
- Kinetics of interaction between ADP-ribosylation factor-1 (Arf1) and the Sec7 domain of Arno guanine nucleotide exchange factor, modulation by allosteric factors, and the uncompetitive inhibitor brefeldin A PMID: 23255605
- The N termini of a-subunit isoforms are involved in signaling between vacuolar H+-ATPase (V-ATPase) and cytohesin-2 PMID: 23288846
- ARNO in turn triggered WAVE regulatory complex recruitment and activation, which was dramatically enhanced when ARNO cooperated with Salmonella SopE. PMID: 22341462
- role for endothelial ARNO in VEGF-dependent initiation of angiogenesis by regulation of VEGFR-2 internalization in endothelial cells, resulting in the activation of the Akt pathway, vessel permeability, and ultimately endothelial proliferation PMID: 22002459
- Data that aldolase forms a complex with ARNO/Arf6 and the V-ATPase and that it may contribute to remodeling of the actin cytoskeleton. PMID: 21307348
- Arno behaves as a bistable switch, having an absolute requirement for activation by an Arf protein but, once triggered, becoming highly active through the positive feedback effect of Arf1-GTP. PMID: 21118813
- cytohesin-2, through a previously unexplored complex formation with paxillin, regulates preadipocyte migration; paxillin plays a previously unknown role as a scaffold protein of Arf guanine-nucleotide exchange factor PMID: 20525696
- Specific motifs of the V-ATPase a2-subunit isoform interact with catalytic and regulatory domains of ARNO. PMID: 20153292
- protein-protein interaction mediated by ARNO coiled-coil domain required for ARNO induced motility; coiled-coil domain promotes assembly of multiprotein complex containing ARNO and Dock180; assembly of complex requires coiled-coil domain, GRASP and IPCEF PMID: 20016009
- The overexpression of ARNO, another mammalian GEF, produces extensive neuritogenesis in Aplysia neurons PMID: 12641750
- cytohesin 2 binds to IPCEF1, which modifies its activity PMID: 12920129
- the N-terminal coiled-coil and parts of the Sec7 domain of cytohesin-2 are required for serum-mediated transcriptional activation in nonimmune cells PMID: 15277685
- Endogenous levels of ARNO/cytohesin-2 present in HEK293 cells are sufficient and necessary for sustained activation of the MAP kinase signaling pathway PMID: 16027149
- The transport and regulation of ARNO in polartized epithelial cells, and its interactions with ARF6 in endocytosis are reported. PMID: 16484220
- Study shows that three related Arf-like GTPases Arl4a, Arl4c, and Arl4d, are able to recruit ARNO and other cytohesins to the plasma membrane by binding to their PH domains irrespective of whether they are in the diglycine or triglycine form. PMID: 17398095
- data suggest cells ruffle upon CaSR (calcium sensing receptor)stimulation via a mechanism that involves translocation of beta-arrestin 1 pre-assembled with the CaSR or ARNO (Arf nucleotide binding site opener) PMID: 17623778
顯示更多
收起更多
-
亞細胞定位:Cell membrane; Peripheral membrane protein. Cytoplasm. Cell projection. Cell projection, growth cone. Cell junction, tight junction. Cell junction, adherens junction.
-
組織特異性:Widely expressed.
-
數(shù)據(jù)庫鏈接:
Most popular with customers
-
Phospho-YAP1 (S127) Recombinant Monoclonal Antibody
Applications: ELISA, WB, IHC
Species Reactivity: Human
-
-
-
-
-
-
-